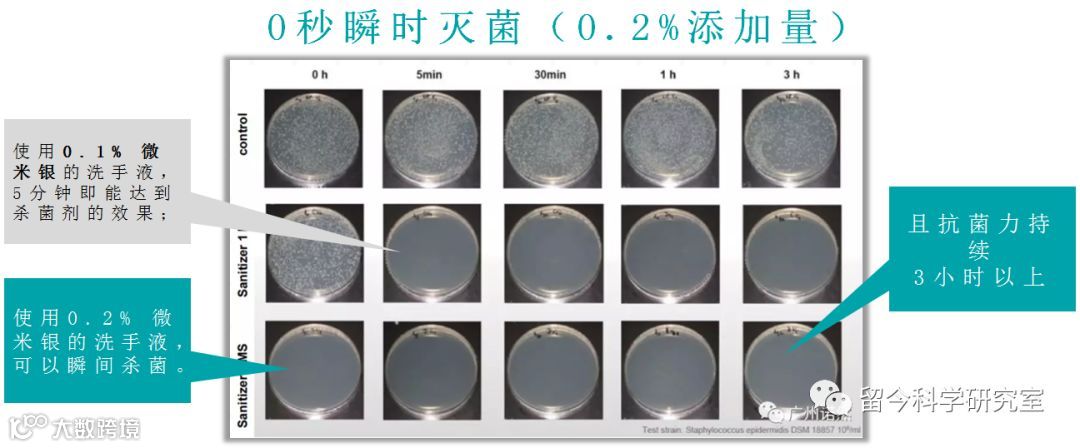

留今科学研究所进行实验测试时,于配方中发现微米银的神奇作用。

利用微米银的强大抗生力进行产品研发。

通过900多次的测试,证实添加了微米银的护肤品对常见病毒、细菌有防护作用。

添加微米银的全效防护产品陆续诞生。

微米银
选择来自德国Bio-Gate最好的微米银,达到医用级99.99%纯度,能够抵抗病毒、革兰氏阴性和阳性菌、真菌与酶母,为肌肤提供全面的保护,一经推出便制霸整个抗生界。



(点击查看大图)
(点击查看大图)

(点击查看大图)
通过超临界自木兰树皮中获得的新型抗菌专利成分,由两种天然分子——木兰醇和厚朴酚异构体组成,具有广泛的抗炎和抗菌功效,纯天然来源,温和无刺激。

(点击查看大图)
水溶性IPMP
来源于麝香草酚的同分异构体,具有优秀的水溶性和广谱的抑菌性能,对各种细菌、酵母菌、真菌以及部分病毒都有显著的抑制作用,安全性更高。

(点击查看大图)
选择我们的8大理由
抗菌久
抑菌强
医疗级


植萃多效防护洗手液





面部抗/抑菌剂





底妆抗/抑菌剂

植萃多效防护隔离霜


头部抗/抑菌剂

身体抗/抑菌剂


※ 此方案仅供营销参考,实际产品包装以符合化妆品非特备案管理法规为准。
感谢阅读


